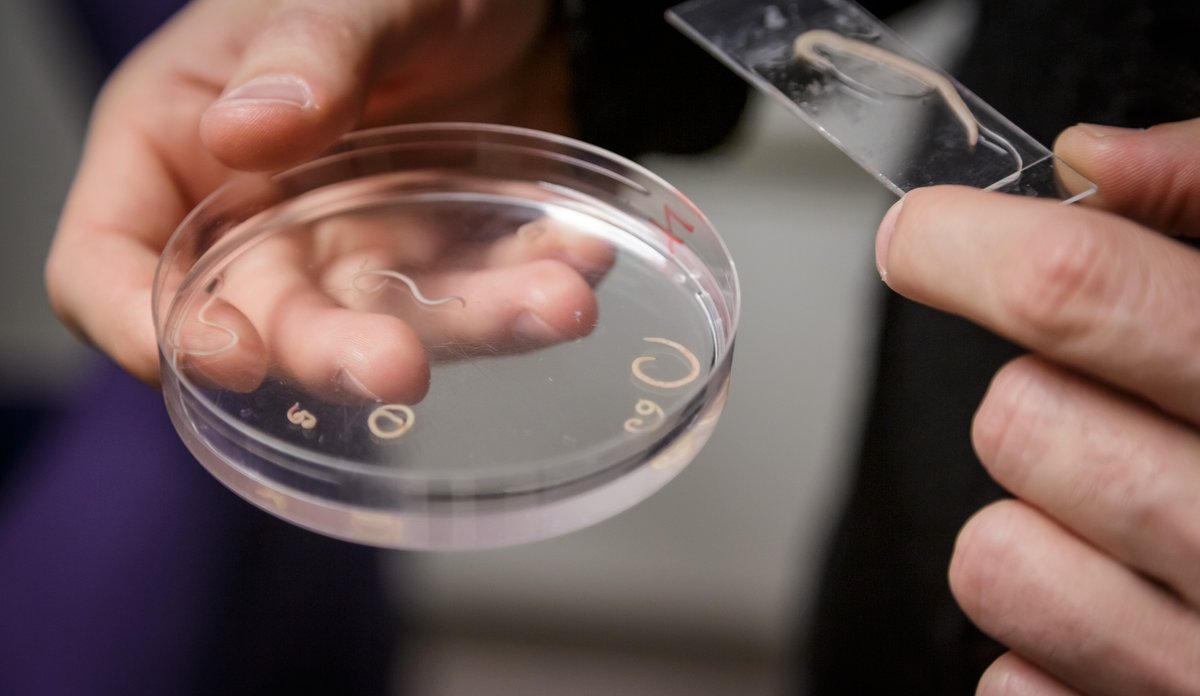
kveis fra sel

Parasitten kveis: Disse larvene kan du finne i fiskekjøttet
Her undersøkes kveis fra en sel som havnet i HIs prøvemottak.
Fotograf: Erlend A. Lorentzen/ HavforskningsinstituttetPublisert: 18.11.2022 Oppdatert: 27.01.2025
For mange oppleves det som svært uappetittlig å oppdage levende mark i fisken de hadde tenkt å spise til middag. Men det er svært vanlig å finne kveis i villfisk som sild, makrell og torsk.
Vanligvis finnes kveis i innvollene hos fisk, og fjernes derfor med sløying. Men parasittene kan også gå over i selve fiskekjøttet.
Kveis er stort sett ufarlig for fisk, men ved store infeksjoner har forskere sett at torsk kan kvitte seg med noe av kveisen ved hjelp av immunforsvaret sitt. Dette kan imidlertid føre til arr i fileten, og gå ut over både vekst og fertilitet hos fisken.
– Vi overvåker kveisutvikling hos villfisk, men for oppdrettsfisk som torsk og kveite er det mer uavklart, sier Arne Levsen.
Sildemark mest vanlig
Den mest vanlige kveisarten er Anisakis simplex, som også kalles for sildemark. Den kan være skummel fordi den kan være vanskelig å få øye på i fiskekjøttet.
Mengden sildemark i et havområde er tett knyttet til mengden småhval, spesielt delfiner, grindhval og spekkhoggere. Disse fungerer som sluttvert for parasitten. Hver hunnmark produserer tusenvis av egg i hvalens tarm, som slippes ut i vannet der de klekkes og frigjør larver.
Etter å ha vært innom krill eller raudåte, havner larvene i fisk og blir til kveis. Kveisinfisert fisk må spises av hval for at livssyklusen skal sluttes. Det er også vanlig at kveisinfisert småfisk som sild, blir spist av større fisk som torsk.
HI overvåker kveis
Havforskningsinstituttet har i en årrekke fulgt med på utviklingen av kveissituasjonen hos viktige fiskeslag som sild, makrell og torsk.
– Det ser ut som situasjonen er ganske stabil for kveis hos sild og makrell i Nordsjøen og Norskehavet, men de senere årene har vi sett en økning av kveis hos torsk fra det sørlige Barentshavet, sier Levsen.
Økningen av sildemark hos skrei henger sammen med at flere småhvaler vandrer inn i Barentshavet om sommeren for å beite på småfisk. Dette kan trolig knyttes til klimaendringene, som igjen har ført til at noen av hvalenes byttedyr trekker lenger og lenger mot nord.
Når flere småhvaler oppholder seg over lengre tid i Barentshavet, vil også mengden kveis som tilføres økosystemet, gradvis øke.
– Når vi vet at enkelte individer av for eksempel grindhval, kan ha hundrevis av eggproduserende sildemark i tarmen sin, sier det seg selv at det blir mye kveis av det, sier Levsen.

Torskemark er større og mer synlig
Den andre vanlige kveistypen hos torsk er Pseudoterranova eller torskemarken. Den er en del større og sterkere farget enn sildemarken, og er dermed lettere å få øye på i fiskekjøttet.
En annen forskjell er at torskemarken bruker ulike selarter og ikke hval som sluttvert.
– I våre undersøkelser har vi så langt ikke funnet tegn på at mengden torskemark er økende. Det kan imidlertid ikke utelukkes at også kystsel som er blant torskemarkens vanligste sluttverter, påvirkes av endringene i økosystemet. God tilgang på mat langs kysten av Nord-Norge, kan gi vekst i bestanden av kystsel over større områder, med økte mengder torskemark som resultat, sier Levsen.

Mennesker kan bli syke
Får man i seg levende kveis ved et uhell ved å for eksempel spise fisk som er fersk og kun lettbehandlet, kan dette føre til magesyke eller allergiske reaksjoner.
Kveisen dør ved varmebehandling til over 60 grader. Det vil si at steking, baking eller trekking i kokende vann er dermed sikre måter å tilberede fisken på så lenge kjernetemperaturen i fiskekjøttet når 60 grader.
Dypfrysing i minst ett døgn vil også ta livet av kveisen. Dersom man planlegger å spise rå eller lettbehandlet villfisk i for eksempel sushi, må man sørge for at fisken har vært fryst ved minus 20 grader.
Hva med sushi?
Norsk oppdrettslaks og regnbueørret som skal brukes i sushi eller liknende, er unntatt fra kravet om frysing. Det unntaket er basert på to landsdekkende undersøkelser gjort av Havforskningsinstituttet i 2014 til 2016 der det ikke ble påvist kveis i hverken laks eller ørret.
Hovedgrunnen er at fisken kun fôres med sterkt varmebehandlet tørrfôr som ikke inneholder levende kveis.
– Hvordan det er med andre arter i oppdrett som for eksempel torsk, er fremdeles uavklart. Torskeoppdrett ligger gjerne i områder der det også er hval og sel, og vi mistenker at oppdrettstorsk i større grad enn laks kan beite på småfisk som forviller seg inn i merdene. Dette igjen kan øke sannsynligheten for at torsken får i seg kveis, sier Levsen.
– Nye undersøkelser bør derfor avklare om unntaket fra frysekravet kan utvides til å omfatte også andre oppdrettsarter som torsk og kveite.




